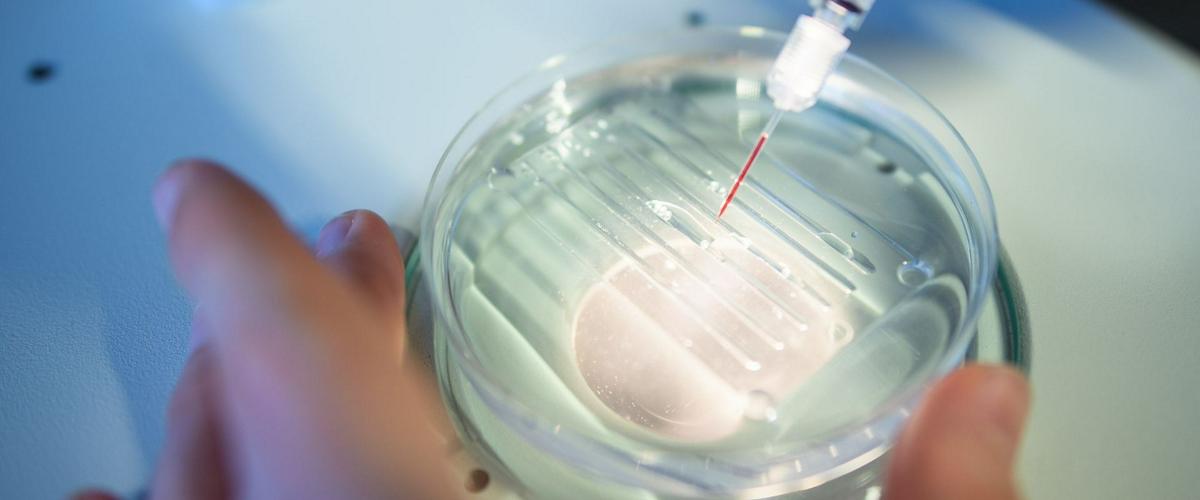
TODO:

Исследователи из MIT и Гарвардского университета научились использовать CRISPR для контроля электронных схем и микрогидродинамических устройств. Созданные на их основе гели могут в заданных обстоятельствах выделять лекарственные средства, белки или живые клетки. Такие материалы можно применять для создания диагностических инструментов или точечной доставки препаратов, рассказывает MIT News.
Группа ученых обратила внимание на фермент Cas12a, который можно запрограммировать на соединение с определенными последовательностями ДНК, меняя цепочку гидовой РНК.
Как только Cas12a сталкивается с нужной последовательностью ДНК, или триггером, она проникает в двойную спираль и трансформируется в фермент, который может разрезать любую одноцепочечную ДНК на своем пути. Таком образом, с ее помощью можно контролировать свойства материалов, меняющиеся в ответ на специфические биологические условия.
Затем был разработаны несколько вариантов гелей с одноцепочечной ДНК. В одном случае он был сделан из полиэтиленгликоля и цеплялся с помощью ДНК к ферментам или другим большим молекулам. После активации триггером Cas12a высвобождает полезный груз.
В другом примере они создали акриламидный гель, в котором одноцепочечная ДНК становится частью структуры геля. В таком случае, когда происходит активация, гель выделяет в большом объеме клетки или наночастицы.
Сейчас ученые проводят исследования, возможно ли использовать этот подход для доставки отредактированных бактериальных клеток в места, пораженные желудочно-кишечными заболеваниями.
Гидрогель для лечения слизистой оболочки тонкого кишечника разработан недавно специалистами из США. Он прилипает к стенкам и может сохранять свои свойства в агрессивной среде в течение нескольких дней.